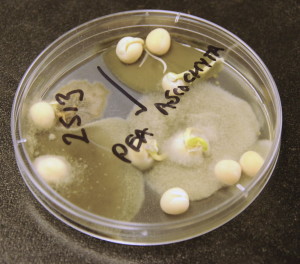

Results from a seed test could shape several management decisions made at seeding — from fine-tuning the seeding rate to determining the viability of the seed lot for seed at all.
Though damaged seeds and vigour issues can be assessed, arguably the biggest factor for consideration in seed test results is the type and level of pathogen presence. But how do we know what to make of test results? And what diseases are we dealing with?
In this Pulse School, Faye Dokken-Bouchard, disease specialist with the Saskatchewan Ministry of Agriculture, shows us what seed tests may reveal and when to consider a seed treatment application to mitigate the risks of crop failure due to disease.
Check out Saskatchewan Ministry of Agriculture’s list of Seed Testing Laboratories on the Prairies.